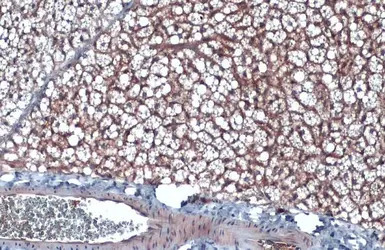
CD36 antibody [C1C3]

相关产品推荐更多 >
万千商家帮你免费找货
0 人在求购买到急需产品
- 详细信息
- 询价记录
- 文献和实验
- 技术资料
- 免疫原:
Carrier-protein conjugated synthetic peptide encompassing a sequence within the C-terminus region of human CD36. The exact sequence is proprietary.
- 亚型:
IgG
- 形态:
Liquid
- 保存条件:
Store as concentrated solution. Centrifuge briefly prior to opening vial. For short-term storage (1-2 weeks), store at 4ºC. For long-term storage, aliquot and store at -20ºC or below. Avoid multiple freeze-thaw cycles.
- 克隆性:
Polyclonal
- 标记物:
Unconjugated
- 适应物种:
Human, Mouse
- 保质期:
12 months from the shipping date of the product.
- 抗原来源:
Human
- 目录编号:
GTX100642
- 级别:
Primary Antibodies
- 库存:
Available
- 供应商:
GeneTex
- 宿主:
Rabbit
- 应用范围:
WB, ICC/IF, IHC-P
- 浓度:
0.47 mg/ml (Please refer to the vial label for the specific concentration.)
- 靶点:
CD36
- 抗体英文名:
CD36 antibody [C1C3]
- 抗体名:
CD36 抗体 [C1C3]
- 规格:
100 μl/25 μl
| 规格: | 100 μl | 产品价格: | ¥4000.0 |
|---|---|---|---|
| 规格: | 25 μl | 产品价格: | ¥1700.0 |

Untreated (–) and treated (+) THP-1 whole cell extracts (30 μg) were separated by 7.5% SDS-PAGE, and the membrane was blotted with CD36 antibody [C1C3] (GTX100642) diluted at 1:1000. The HRP-conjugated anti-rabbit IgG antibody (GTX213110-01) was used to detect the primary antibody, and the signal was developed with Trident ECL plus-Enhanced.
CD36 antibody [C1C3] detects CD36 protein by immunohistochemical analysis.
Sample: Paraffin-embedded mouse brown adipocyte.
CD36 stained by CD36 antibody [C1C3] (GTX100642) diluted at 1:500.
Antigen Retrieval: Citrate buffer, pH 6.0, 15 min

Immunohistochemical analysis of paraffin-embedded Ca922 xenograft, using CD36(GTX100642) antibody at 1:500 dilution.
Antigen Retrieval: Trilogy™ (EDTA based, pH 8.0) buffer, 15min

Immunofluorescence analysis of PFA-fixed mouse ESC D3, using CD36(GTX100642) antibody at 1:200 dilution.

Unstimulatd and stimulatd 3T3-L1 whole cell extracts (20 μg) were separated by 10% SDS-PAGE, and the membrane was blotted with CD36 antibody [C1C3] (GTX100642) diluted at 1:500. The HRP-conjugated anti-rabbit IgG antibody (GTX213110-01) was used to detect the primary antibody. (The differentiation stimulated medium is composed by basal medium, 10% FBS, 50 ug/ml gentamicin, 1 nM L-glutamin, 500 uM IBMX, 1 uM dexamethasone, 2 uM rosiglitazone and 1 ug/ml insulin.)

Mouse tissue extract (50 μg) was separated by 7.5% SDS-PAGE, and the membrane was blotted with CD36 antibody [C1C3] (GTX100642) diluted at 1:1000.

Various tissue extracts (50 μg) were separated by 7.5% SDS-PAGE, and the membrane was blotted with CD36 antibody [C1C3] (GTX100642) diluted at 1:500. The HRP-conjugated anti-rabbit IgG antibody (GTX213110-01) was used to detect the primary antibody.
风险提示:丁香通仅作为第三方平台,为商家信息发布提供平台空间。用户咨询产品时请注意保护个人信息及财产安全,合理判断,谨慎选购商品,商家和用户对交易行为负责。对于医疗器械类产品,请先查证核实企业经营资质和医疗器械产品注册证情况。
- 作者
- 内容
- 询问日期
 文献和实验
文献和实验Du RH et al., Atherosclerosis 2014 (PMID:24637412)
Vaillant F et al., Am J Physiol Heart Circ Physiol 2014 (PMID:24186097)
Kiyan Y et al., J Mol Cell Cardiol 2014 (PMID:24239845)
Kouadir M et al., PLoS One 2012 (PMID:22292032)
Rodriguez-Lopez C et al., J Physiol 2023 (PMID:36370371)
Sui D et al., Bioengineered 2022 (PMID:35707830)
Wael Ageeli et al., Front Oncol 2022 (PMID:35530322)
Njau F et al., Antioxidants (Basel) 2021 (PMID:34829669)
Tsai YT et al., Nutrients 2020 (PMID:32164196)
Brusini R et al., Int J Pharm 2020 (PMID:32259640)
Tsukahara T et al., Cell Signal 2020 (PMID:31666203)
Xu M et al., Cardiovasc Res 2018 (PMID:30165480)
Sun Q et al., Gene 2018 (PMID:29969695)
Gui Y et al., Cardiovasc Res 2016 (PMID:27460841)
Gui YZ et al., Acta Pharmacol Sin 2016 (PMID:27374487)
Talukder MA et al., Physiol Rep 2016 (PMID:27033451)
人可溶性CD36 分子 ( sCD36 )ELISA 试剂盒 ( 用于血清、血浆、细胞培养上清液和其它生物体液内 ) 原理 本实验采用双抗体夹心 ABC-ELISA 法。用抗人 sCD36 单抗包被于酶标板上,标准品和样品中的 sCD36与单抗结合,加入生物素化的抗人 sCD36 ,形成免疫复合物连接在板上,辣根过氧化物酶标记的 Streptavidin 与生物素结合,加入底物工作液显蓝
小鼠可溶性CD36分子(sCD36)ELISA试剂盒 说明书
上海西唐生物科技有限公司 021-55229872, 65333639 www.westang.com 小鼠可溶性CD36 分子 ( sCD36 )ELISA 试剂盒 ( 用于血清、血浆、细胞培养上清液和其它生物体液内 ) 原理 本实验采用双抗体夹心 ABC-ELISA 法。用抗小鼠 sCD36 单抗包被于酶标板上,标准品和样品中的 sCD36与单抗结合,加入生物
Native Chromatin Preparation and Illumina/Solexa Library Construction
Antibody and preimmune serum for ChIP CD4+ T cell Isolation Kit II (human) (Miltenyi Biotec) Alternatively, Dynabeads Untouched Human CD4 T Cells Kit (Invitrogen) can be used (see Steps 5-21). DNA End-Repair Kit (Epicentre Biotechnologies
 技术资料
技术资料暂无技术资料 索取技术资料





![CD80 antibody [MEM-233] (PE)](https://img1.dxycdn.com/2022/0329/472/4435777754626020453-14.jpg!wh200)
![Desmin antibody [10H7D2]](https://img1.dxycdn.com/2022/0328/168/5095840721257500453-14.jpg!wh200)
![Aldolase C antibody [AT2E11]](https://img1.dxycdn.com/2022/0328/710/2769849842360800453-14.jpg!wh200)
![TIGIT antibody [1G9] (PE)](https://img1.dxycdn.com/2022/0328/887/6369046577776700453-14.jpg!wh200)
![GOT2 antibody [AT8B11]](https://img1.dxycdn.com/2022/0328/713/4748466857760800453-14.jpg!wh200)
